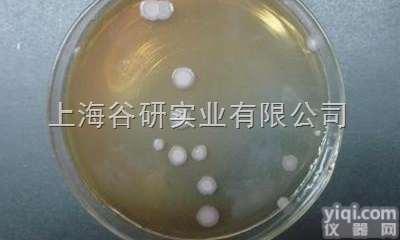
粪肠球菌（粪<em>链球菌</em>）<em>运输</em>

马链球菌马亚种 ATCC 9528运输
- 品牌:DSMZ
- 产地:进口、国产
- 供应商:上海谷研实业有限公司
- 供应商报价:面议
- 标签:马链球菌马亚种 ATCC 9528运输,555,上海谷研实业有限公司
我公司专业代理ATCC菌种,马链球菌马亚种 ATCC 9528运输,质量保证,为大中型科研提供严格质量体系控制的ATCC,CMCC,CICC,DSMZ标准菌株。欢迎广大科研用户!
产品名称 | 马链球菌马亚种 ATCC 9528运输 |
规格 | 5支/包装 |
货期 | 3-5天 |
【产品规格】:5支/包装
【中文名称】:马链球菌马亚种 ATCC 9528运输
【英文名称】:无
【CAS.编号】:无
【详细描述】: Culti-Loops 质控菌株接种环为5支/包装,除弯曲菌属需冷冻保存(-18℃)外,其它都应在2-8℃保存。
使用范围:仅供科研使用
库存:提供现货(因销量问题库存会有变动,具体请与销售人员确认)
保存:低温避光保存
马链球菌马亚种 ATCC 9528运输【标准操作流程】
菌株复苏:(按三区划线法将留菌管内的原始菌株进行复苏)
1) 所有菌株,显色培养基分4区,每区一株,标明菌株号、菌种名常用缩写如下:
cal: 白念珠菌 cgl:光滑念珠菌 cpa: 近平滑念珠菌 ctr: 热带念珠菌 ckr: 克柔念珠菌 cne: 新型隐球菌,其他菌种标记全名
2) 隐球菌除传显色培养基以外,另传1/2块血平皿上述菌株统一37oC孵育48h
菌种鉴定:(48h后观察结果)
存储:低温,清洁肯干燥的地方(室温放置时间过长会导致菌种衰退)。
有限期:3-6个月(应根据菌种状况及时转接,冻干菌种保藏时间通常为2-25年)
1)供货及时。我们订货周期短,运输时间短,在Z短时间内为您提供所需产品。
2)价格优惠:我公司是ScienCell和美国ATCC的ZG代理商,没有中间环节。在国内我们保证价格Z低。
3)服务保障:我们拥有专用的技术指导团队,对每售出的一件产品,提供全面的售前、售中和售后服务。
马链球菌马亚种 ATCC 9528运输显色培养结果:
cal:绿色 ctr:蓝色 ckr:粉色 cgl:紫色
2) 隐球菌在血平皿上为透明白色偏小的菌落
若不纯或出现污染,传半块显色/血平皿分纯,37oC孵育48h。显色不典型或与原始结果判读不一致的菌株,做记录并向实验负责人反应确认
马链球菌马亚种 ATCC 9528运输经公司实验室亲自验证过,可以提供。实验室的热点需求,我司结合当前科研试剂的发展现状与市场需求,加大实验室建设和配置的的投入。供应产品有:ELISA试剂盒、生物试剂、标准品/对照品、细胞、培养基、菌种、抗体等生物领域应用试剂。
IGFBP-1(Mouse Insulin-like growth factor binding protein 1) ELISA Kit 小鼠胰岛素样生长因子结合蛋白1Multi-class antibodies规格: 48T
Anti-CCL27/CTACK/FITC 荧光素标记皮肤T细胞虏获趋化因子抗体IgGMulti-class antibodies规格: 0.2ml
Rhesus antibody Rh EDG7/LPA3 溶血磷脂酸受体蛋白3抗体 规格 0.2ml
AFP-L1 ELISA Kit 小鼠小扁豆素结合型甲胎蛋白/甲胎蛋白异质体1 96T
MEGF5 英文名称: 复合型表皮生长因子样结构域蛋白5抗体 0.2ml
phospho-ATF1 (Ser63) 英文名称: 磷酸化活化转录因子1抗体 0.1ml
Anti-CCL27/CTACK/FITC 荧光素标记皮肤T细胞虏获趋化因子抗体IgGMulti-class antibodies规格: 0.2ml
ANG-1(Human Angiopoietin 1) ELISA Kit 人血管生成素1Multi-class antibodies规格: 48T
Phospho-PAK4 (Ser474)/PAK5 (Ser602)/PAK6 (Ser560) 磷酸化p21激活激酶4、5、6抗体Multi-class antibodies规格: 0.1ml
Rhesus antibody Rh Hpt/Haptoglobin 结合珠蛋白/触珠蛋白抗体 规格 0.1ml
ATGA/TGAB ELISA Kit 大鼠抗甲状腺球蛋白抗体 96T
Phospho-PDGFRA(Tyr849)/PDGFRB(Tyr857) 英文名称: 磷酸化血小板源性生长因子受体α/β抗体 0.1ml
CACNB4 英文名称: L型电压依赖型钙通道β4抗体 0.2ml
Phospho-PAK4 (Ser474)/PAK5 (Ser602)/PAK6 (Ser560) 磷酸化p21激活激酶4、5、6抗体Multi-class antibodies规格: 0.1ml
SCN8A 英文名称: 钠通道蛋白8α抗体 0.1ml
Anei-ENPP2 英文名称: 自分泌运动因子抗体 0.1ml
肺表面活性蛋白B抗体 Anti-SP-B 0.1ml
Anti-TGM3/FITC 荧光素标记转谷氨酰酶3抗体IgGMulti-class antibodies规格: 0.2ml
Rhesus antibody Rh phospho-MAP4K4(Ser629) 磷酸化原活化蛋白激酶MAP4K4抗体 规格 0.1ml
phospho-ATF2(pSer490/pSer498) 磷酸化活化复制因子2抗原Multi-class antibodies规格: 0.5mg
OXR (Orexin receptor) 食欲素受体(多肽)Multi-class antibodies规格: 0.5mg
Anti-ARIP2B 激活素受体2B抗体Multi-class antibodies规格: 0.2ml
Rhesus antibody Rh phospho-ASAP1/DDEF1(Tyr782) 磷酸化发育分化增强因子1抗体 规格 0.1ml
Troponin I 浓缩液 0.1ml 进口分装
ULBP1 英文名称: UL16结合蛋白1蛋白抗体 0.1ml
ASMTY 英文名称: 松果体N甲基乙酰羟色胺抗体 0.2ml
Anti-ARIP2B 激活素受体2B抗体Multi-class antibodies规格: 0.2ml
乳糖发酵培养基22050250g用于多管发酵法测定食品、纯净水和一次性使用卫生用品中大肠菌群的确证试验
庖肉培养基 (CM0081) Oxoid incubation media 庖肉培养基 (CM0081) Oxoid
泡盛曲霉烟色变种 用于制酒 支/瓶
月桂基盐蛋白胨肉汤-MUGl用于O测,(GB标准)
BairdParkerAgarMedium
四号琼脂基础250g用于霍乱弧菌的选择性分离,后加亚碲酸钾
BRILA broth brilliant green-bile-lactcose broth 亮绿乳糖胆盐肉汤 1.05454.0500 MERCK默克 incubation media BRILA broth brilliant green-bile-lactcose broth 亮绿乳糖胆盐肉汤 1.05454.0500 MERCK默克
胰蛋白胨大豆琼脂培养基 250g 用于普通的或营养要求较高的细菌的培养,还用于医药工业洁净室无菌程度的监
盐胱酸增菌液SC20支/包用于沙门氏菌选择性增菌培养
假单胞分离肉汤 250g 用于假单胞菌群增菌培养
YM11琼脂 YM11 Agar 250 滤膜法用于霉菌、酵母菌的分离培养(NEOGEN方法)
Eugon琼脂250g/瓶广泛用于微生物的培养incubationmediaEugon琼脂250g/瓶广泛用于微生物的培养
ThiosulfateCitrateBileSaltsSucroseAgar
马链球菌马亚种 ATCC 9528运输EC肉汤250g用于粪大肠菌群、大肠杆菌的测定(GB、SN标准)
强化梭菌鉴别琼脂(DRCA) Differentia Reinforced Clostridial Agar 用于食品和其它物质中梭菌的计数和培养(MERCK方法)
胰酶大豆琼脂 TSA 250克 用于生物制品的无菌试验
乳糖蛋白胨培养液用于饮用水,水源水中总大肠菌群的测定(GB标准)incubationmedia乳糖蛋白胨培养液用于饮用水,水源水中总大肠菌群的测定(GB标准)
TMP琼脂培养基 250g 用于金黄色葡萄球菌的分离培养